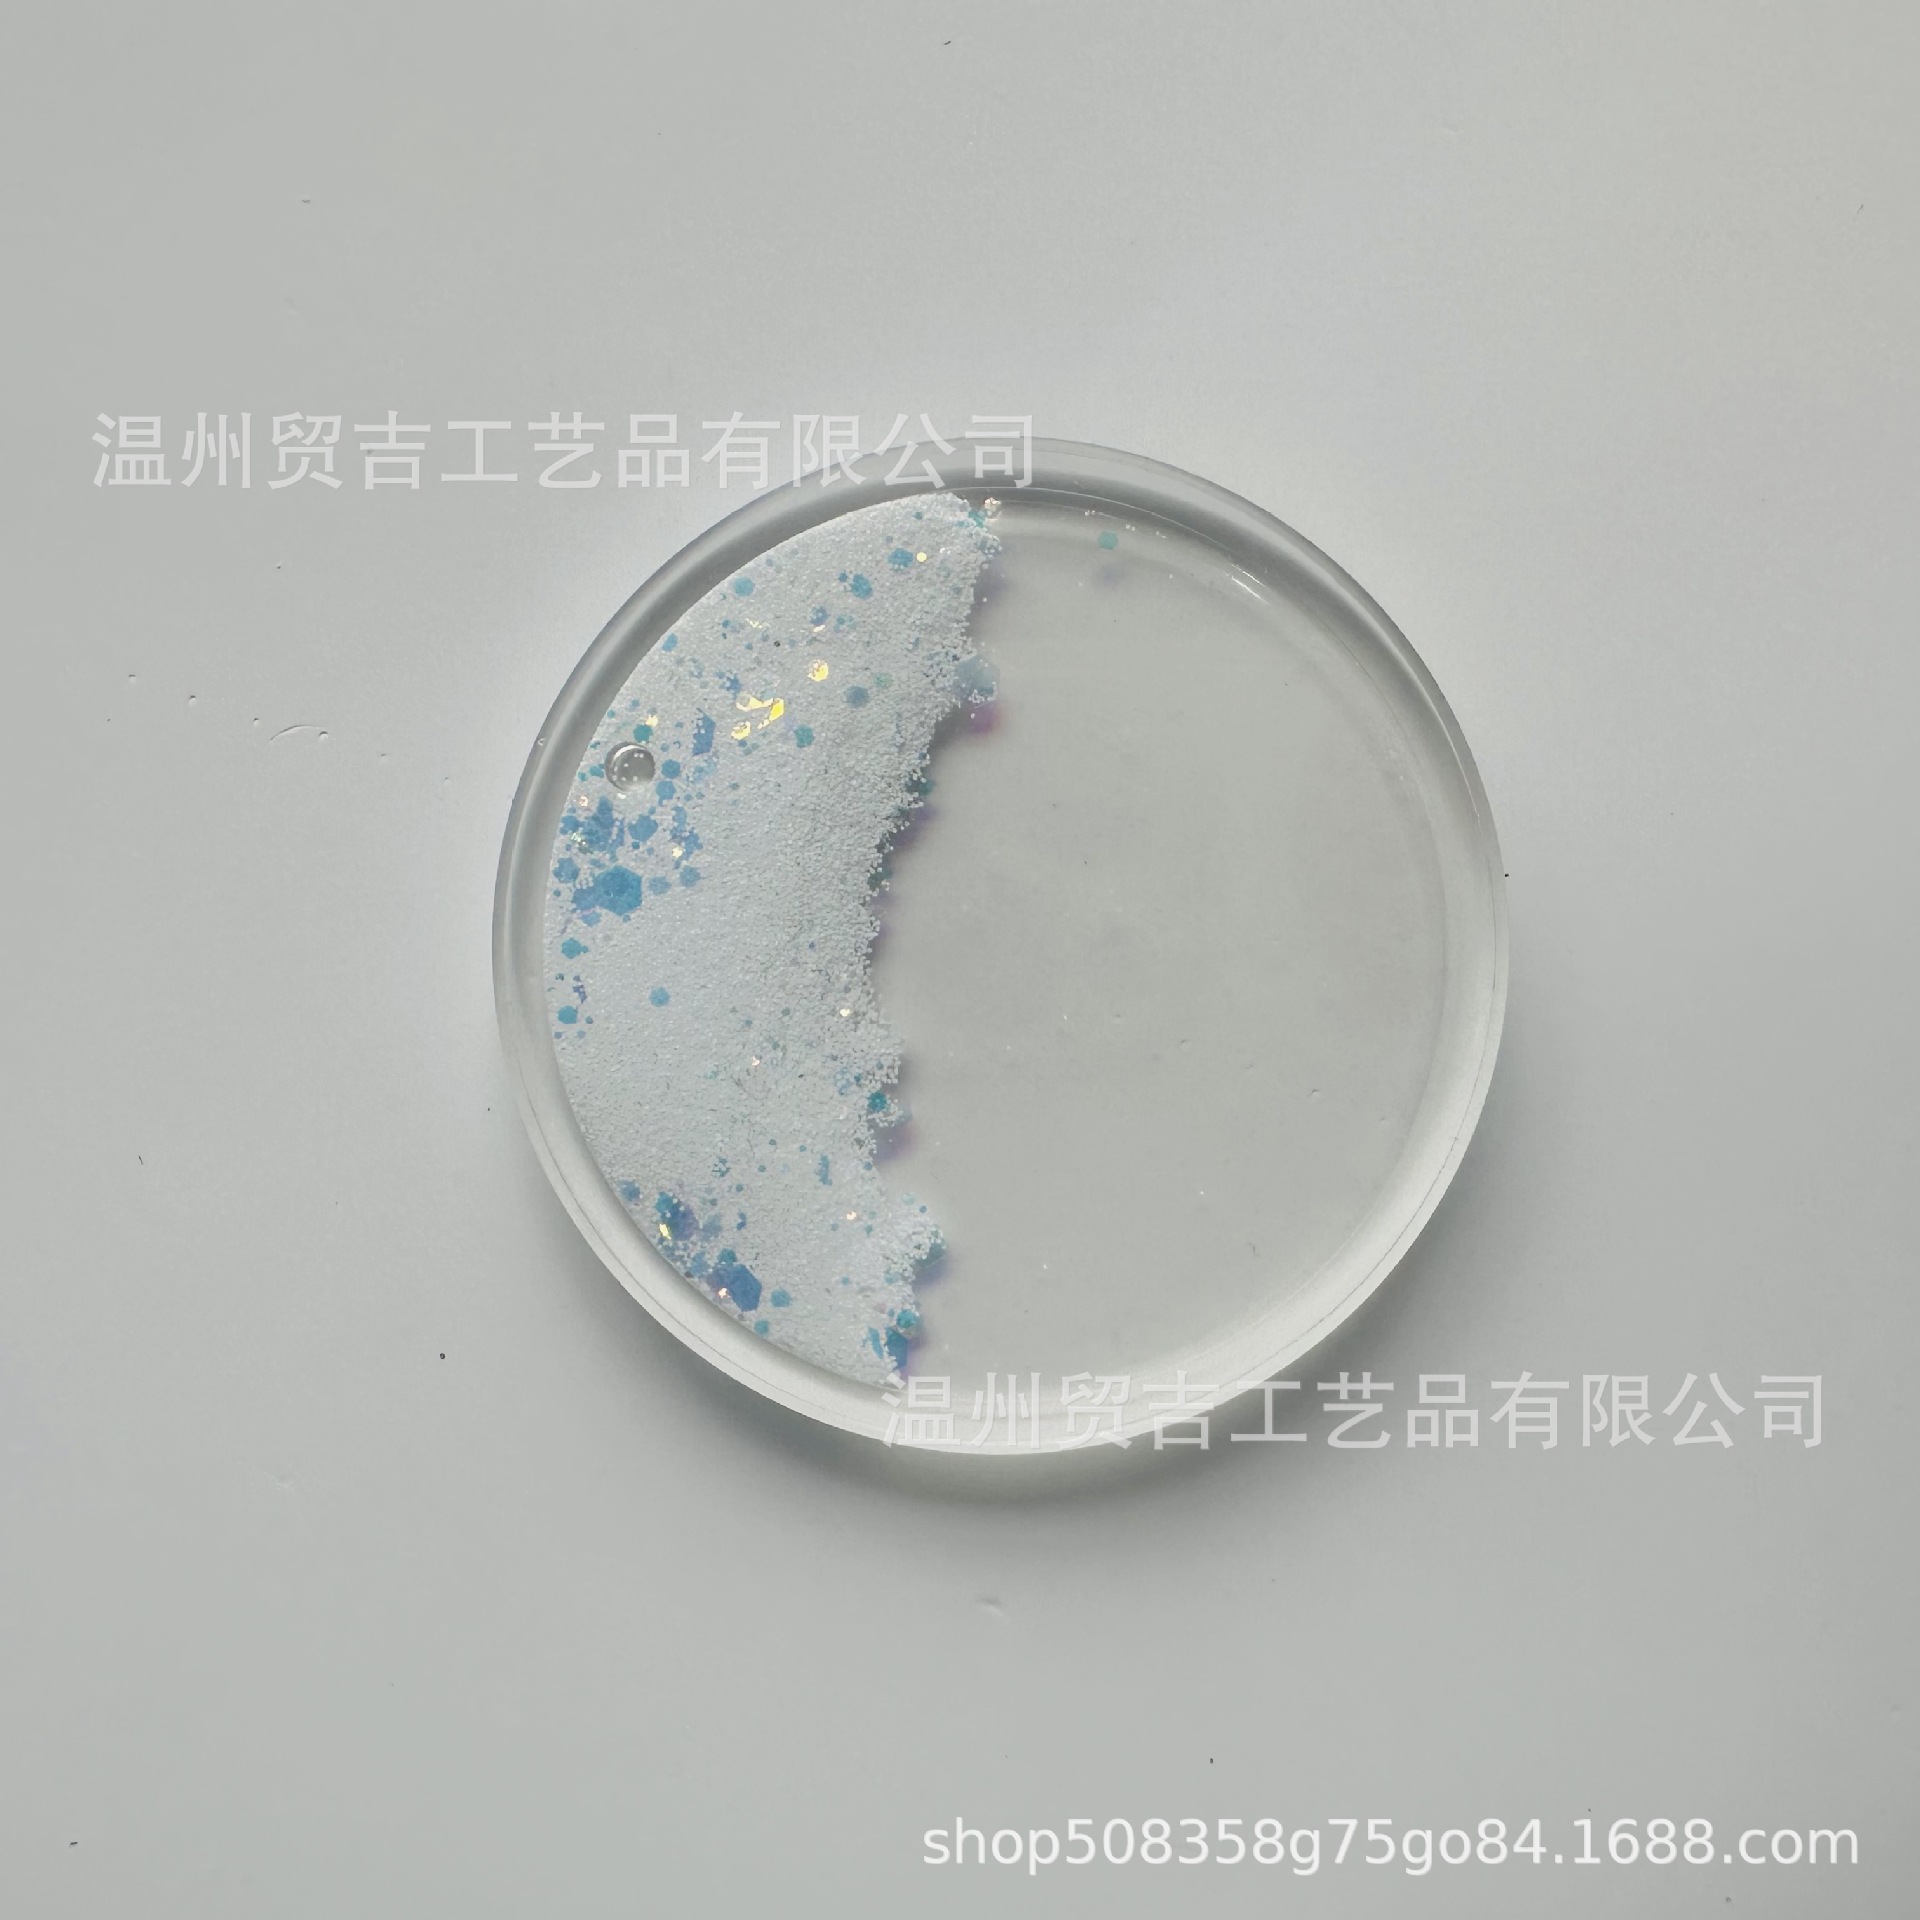
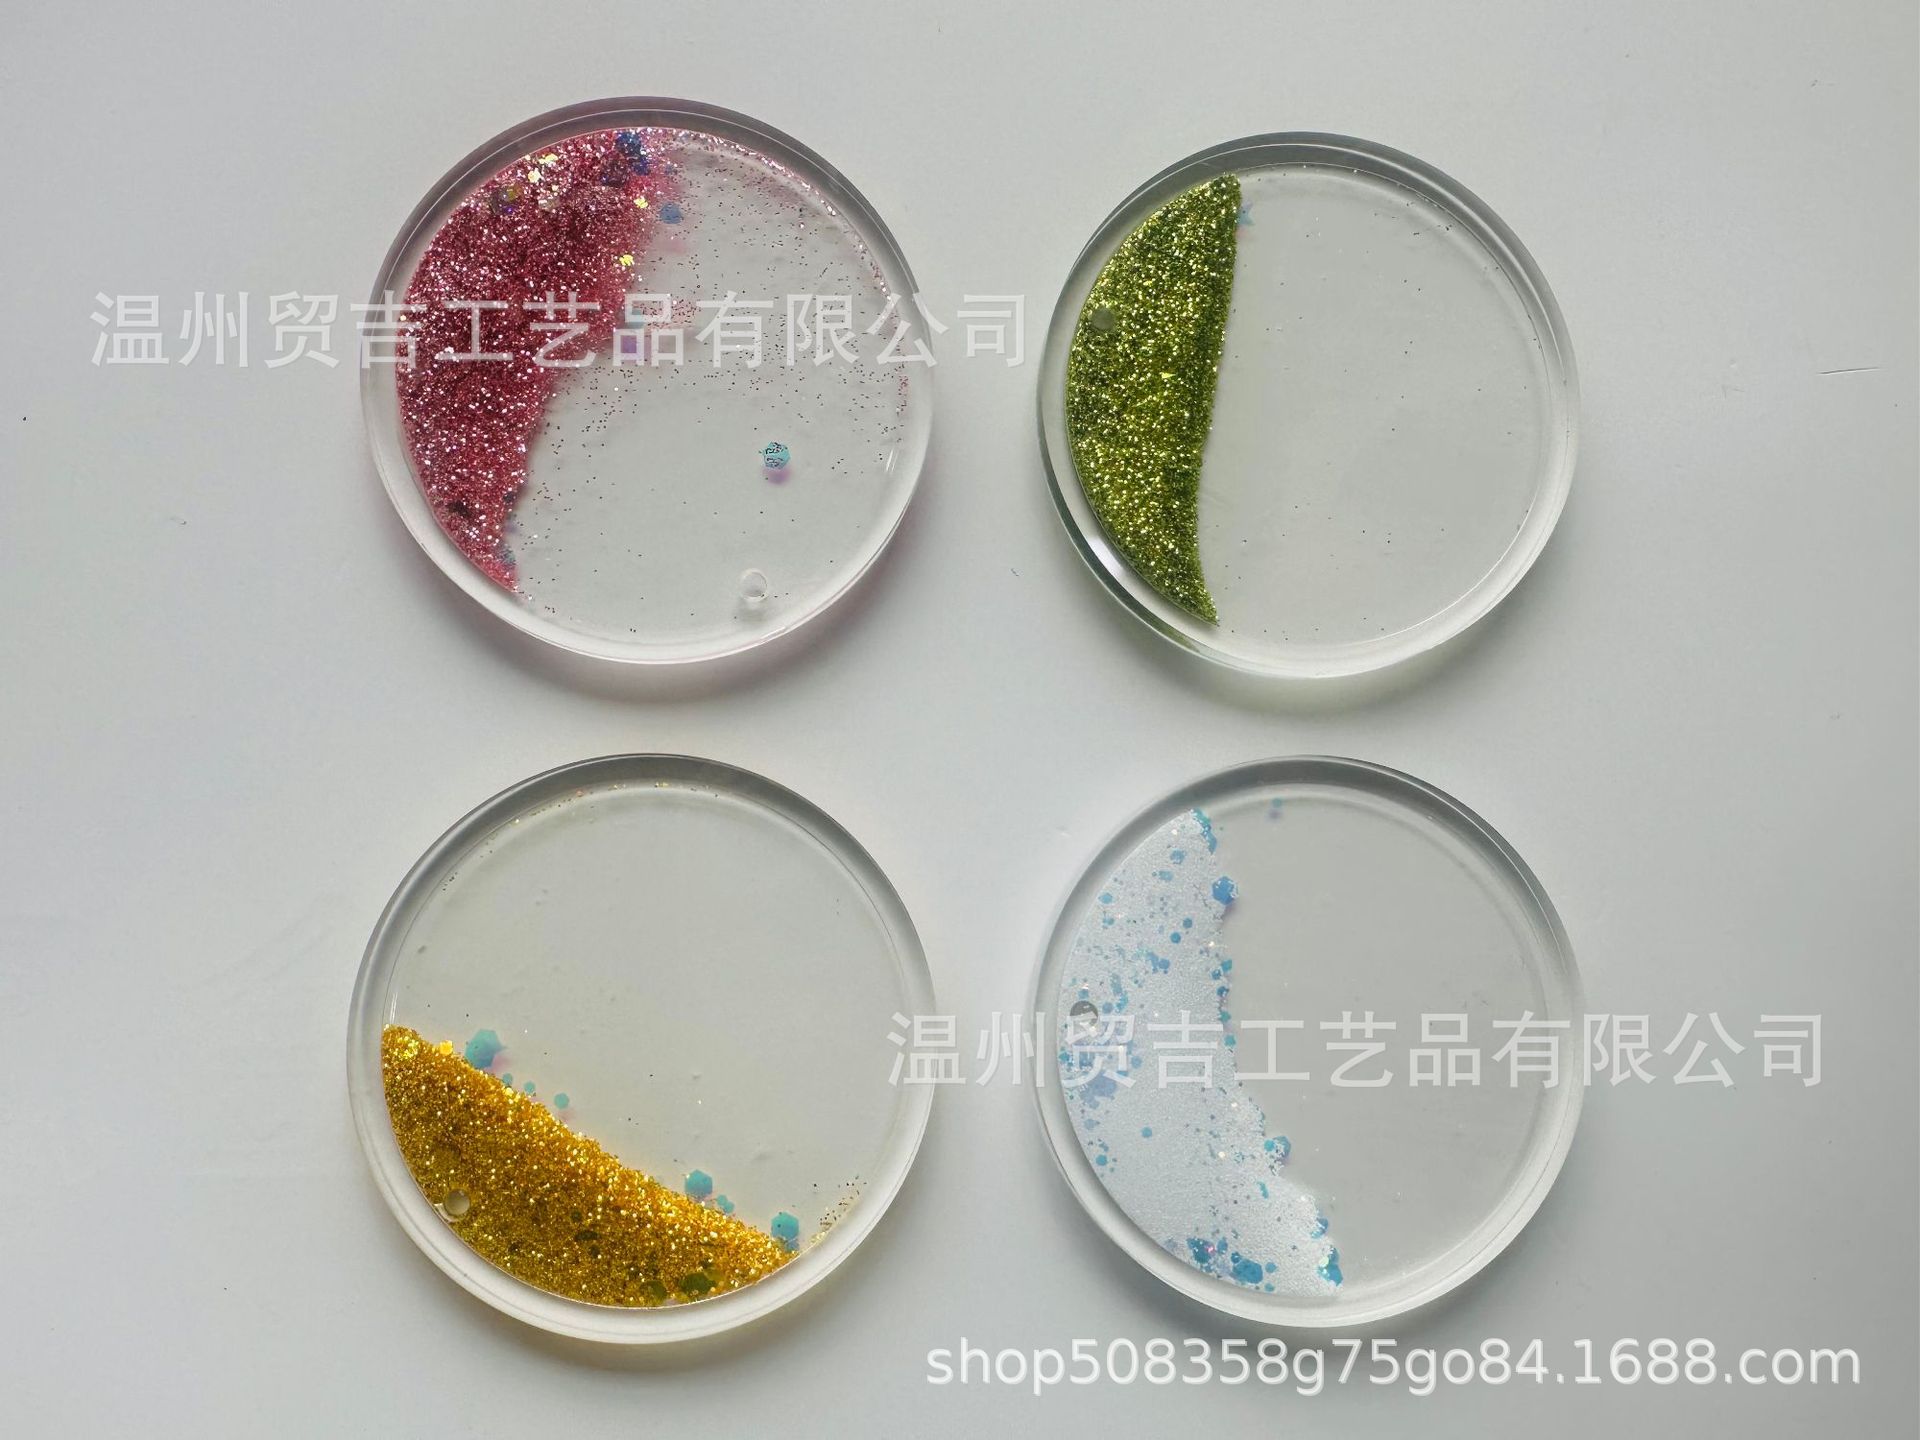

Индивидуальная деталь для маджонга с песком, акриловый маджонг с высокой прозрачностью и потоком, DIY форма
Цена
¥1.00 / ≈ 12 ₽
MOQ: 1 pcs
1шт - ¥1.00
Продавец
温州贸吉工艺品有限公司
Рейтинг
0
Продано
22200
Всего
В наличии
99200
SKU суммарно
Offer ID: 991383422993
Оформить заказ
Цвет:
| Изображение | Цвет | Цена (CNY / RUB) | В наличии | SKU ID | Кол-во / Корзина |
|---|---|---|---|---|---|
📦 | Please contact customer service for customization | ¥2.0 / ≈ 24 ₽ | 99000 | 5964271733062 | |
 | Existing samples are sent randomly (not necessarily the picture style) | ¥1.0 / ≈ 12 ₽ | 200 | 5964271733063 |
Статистика продавца
4.0
Сервис
Источник: API 1688
5.0
Логистика
Источник: API 1688
5.0
Споры
Источник: API 1688
5.0
Оформление
Источник: API 1688
2.0
Консультация
Источник: API 1688
41%
Повторные покупки
Источник: API 1688
5.0
Постпродажное
Источник: API 1688
0%
Возврат по качеству (30д)
Источник: API 1688
Свойства товара
Бренд Other
Запатентованный источник? No
Материал Acrylic
Обработка и настройка Yes
Номер товара -
Подходит для подарков Full moon, Travel commemorative, Graduation, Moving house, Party gathering, Get well soon
Подходит для подарков в отношениях Junior, Couple, Colleague, Friend, Elders, Child, Classmate, Mentor
Применимые праздники Christmas, Valentine's day, Spring festival, Father's day, Mother's day, Teachers' day, New year's day, Chinese valentine's day, Halloween, Easter, National day, Children's day, Women's day
Является ли это подарком Yes, personal gifts
Авторизован ли IP No
Переплет Bag
Описание товара